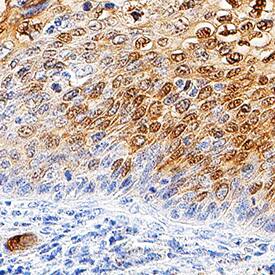
Galectin-7 antibody in Human Cervical Cancer Tissue by Immunohistochemistry (IHC-P).

Human Galectin-7 Antibody
R&D Systems, part of Bio-Techne | Catalog # MAB13391


Key Product Details
Species Reactivity
Applications
Validated:
Cited:
Label
Antibody Source
Product Specifications
Immunogen
Ser26-Phe136
Accession # NP_002298
Specificity
Clonality
Host
Isotype
Scientific Data Images for Human Galectin-7 Antibody
Detection of Human Galectin-7 by Western Blot.
Western blot shows lysates of human skin tissue and human skin cancer tissue. PVDF membrane was probed with 2 µg/mL of Mouse Anti-Human Galectin-7 Monoclonal Antibody (Catalog # MAB13391) followed by HRP-conjugated Anti-Mouse IgG Secondary Antibody (Catalog # HAF018). A specific band was detected for Galectin-7 at approximately 14 kDa (as indicated). This experiment was conducted under reducing conditions and using Immunoblot Buffer Group 1.Galectin‑7 in HEK001 Human Cell Line.
Galectin-7 was detected in immersion fixed HEK001 human skin kerotinocyte cell line using Mouse Anti-Human Galectin-7 Monoclonal Antibody (Catalog # MAB13391) at 5 µg/mL for 3 hours at room temperature. Cells were stained using the NorthernLights™ 557-conjugated Anti-Mouse IgG Secondary Antibody (red; Catalog # NL007) and counterstained with DAPI (blue). Specific staining was localized to cytoplasm and nuclei. View our protocol for Fluorescent ICC Staining of Cells on Coverslips.Galectin‑7 in Human Cervical Cancer Tissue.
Galectin-7 was detected in immersion fixed paraffin-embedded sections of human cervical cancer tissue using Mouse Anti-Human Galectin-7 Monoclonal Antibody (Catalog # MAB13391) at 5 µg/mL overnight at 4 °C. Tissue was stained using the Anti-Mouse HRP-DAB Cell & Tissue Staining Kit (brown; Catalog # CTS002) and counterstained with hematoxylin (blue). Specific staining was localized to cytoplasm and nuclei. View our protocol for Chromogenic IHC Staining of Paraffin-embedded Tissue Sections.Applications for Human Galectin-7 Antibody
Immunocytochemistry
Sample: Immersion fixed HEK001 human skin keratinocyte cell line
Immunohistochemistry
Sample: Immersion fixed paraffin-embedded sections of human cervical cancer tissue
Western Blot
Sample: Human skin tissue and human skin cancer tissue
Formulation, Preparation, and Storage
Purification
Reconstitution
Formulation
Shipping
Stability & Storage
- 12 months from date of receipt, -20 to -70 °C as supplied.
- 1 month, 2 to 8 °C under sterile conditions after reconstitution.
- 6 months, -20 to -70 °C under sterile conditions after reconstitution.
Background: Galectin-7
The galectins constitute a large family of carbohydrate-binding proteins with specificity for N-acetyl-lactosamine-containing glycoproteins. At least 14 mammalian galectins, which share structural similarities in their carbohydrate recognition domains (CRD), have been identified. The galectins have been classified into the prototype galectins (-1, -2, -5, -7, -10, -11, -13, -14), which contain one CRD and exist either as a monomer or a noncovalent homodimer; the chimera galectins (Galectin-3) containing one CRD linked to a nonlectin domain; and the tandem-repeat galectins (-4, -6, -8, -9, -12) consisting of two CRDs joined by a linker peptide. Galectins lack a classical signal peptide and can be localized to the cytosolic compartments where they have intracellular functions. However, via one or more as yet unidentified non-classical secretory pathways, galectins can also be secreted to function extracellularly. Individual members of the galectin family have different tissue distribution profiles and exhibit subtle differences in their carbohydrate-binding specificities. Each family member may preferentially bind to a unique subset of cell-surface glycoproteins (1-4). Human Galectin-7 is a prototype monomeric galectin. It is specifically expressed in stratified epithelia, notably in epidermis, but is barely detectable in epidermal tumors and significantly down regulated or absent from squamous carconima cell lines. The Galectin-7 gene is induced by tumor suppressor protein p53 transcriptional activity following genotoxic events. A pro-apoptotic protein, Galectin-7 functions intracellularly upstream of JNK activation and cytochrome-c release. This protein has been shown to increase the susceptibility of keratinocytes to UVB induced apoptosis, an essential processss in the maintenance of epidermal homeostasis. Cell lines transfected with the Galectin-7 gene localized the protein in the nucleus and intracellularly. Human and mouse Galectin-7 share 79% amino acid homology (4-6).
References
- Rabinovich, A. et al. (2002) TRENDS in Immunol. 23:313.
- Rabinovich, A. et al. (2002) J. Leukocyte Biology 71:741.
- Hughes, R.C. (2002) Biochimie 83:667.
- R&D Systems Cytokine Bulletin; Summer 2002.
- Bernerd, F. et al. (1999) Proc. Natl. Acad. Sci. USA 96:11329.
- Kuwabara, I. et al. (2002) J. Biol. Chem. 277:3487.
Alternate Names
Gene Symbol
UniProt
Additional Galectin-7 Products
Product Documents for Human Galectin-7 Antibody
Product Specific Notices for Human Galectin-7 Antibody
For research use only